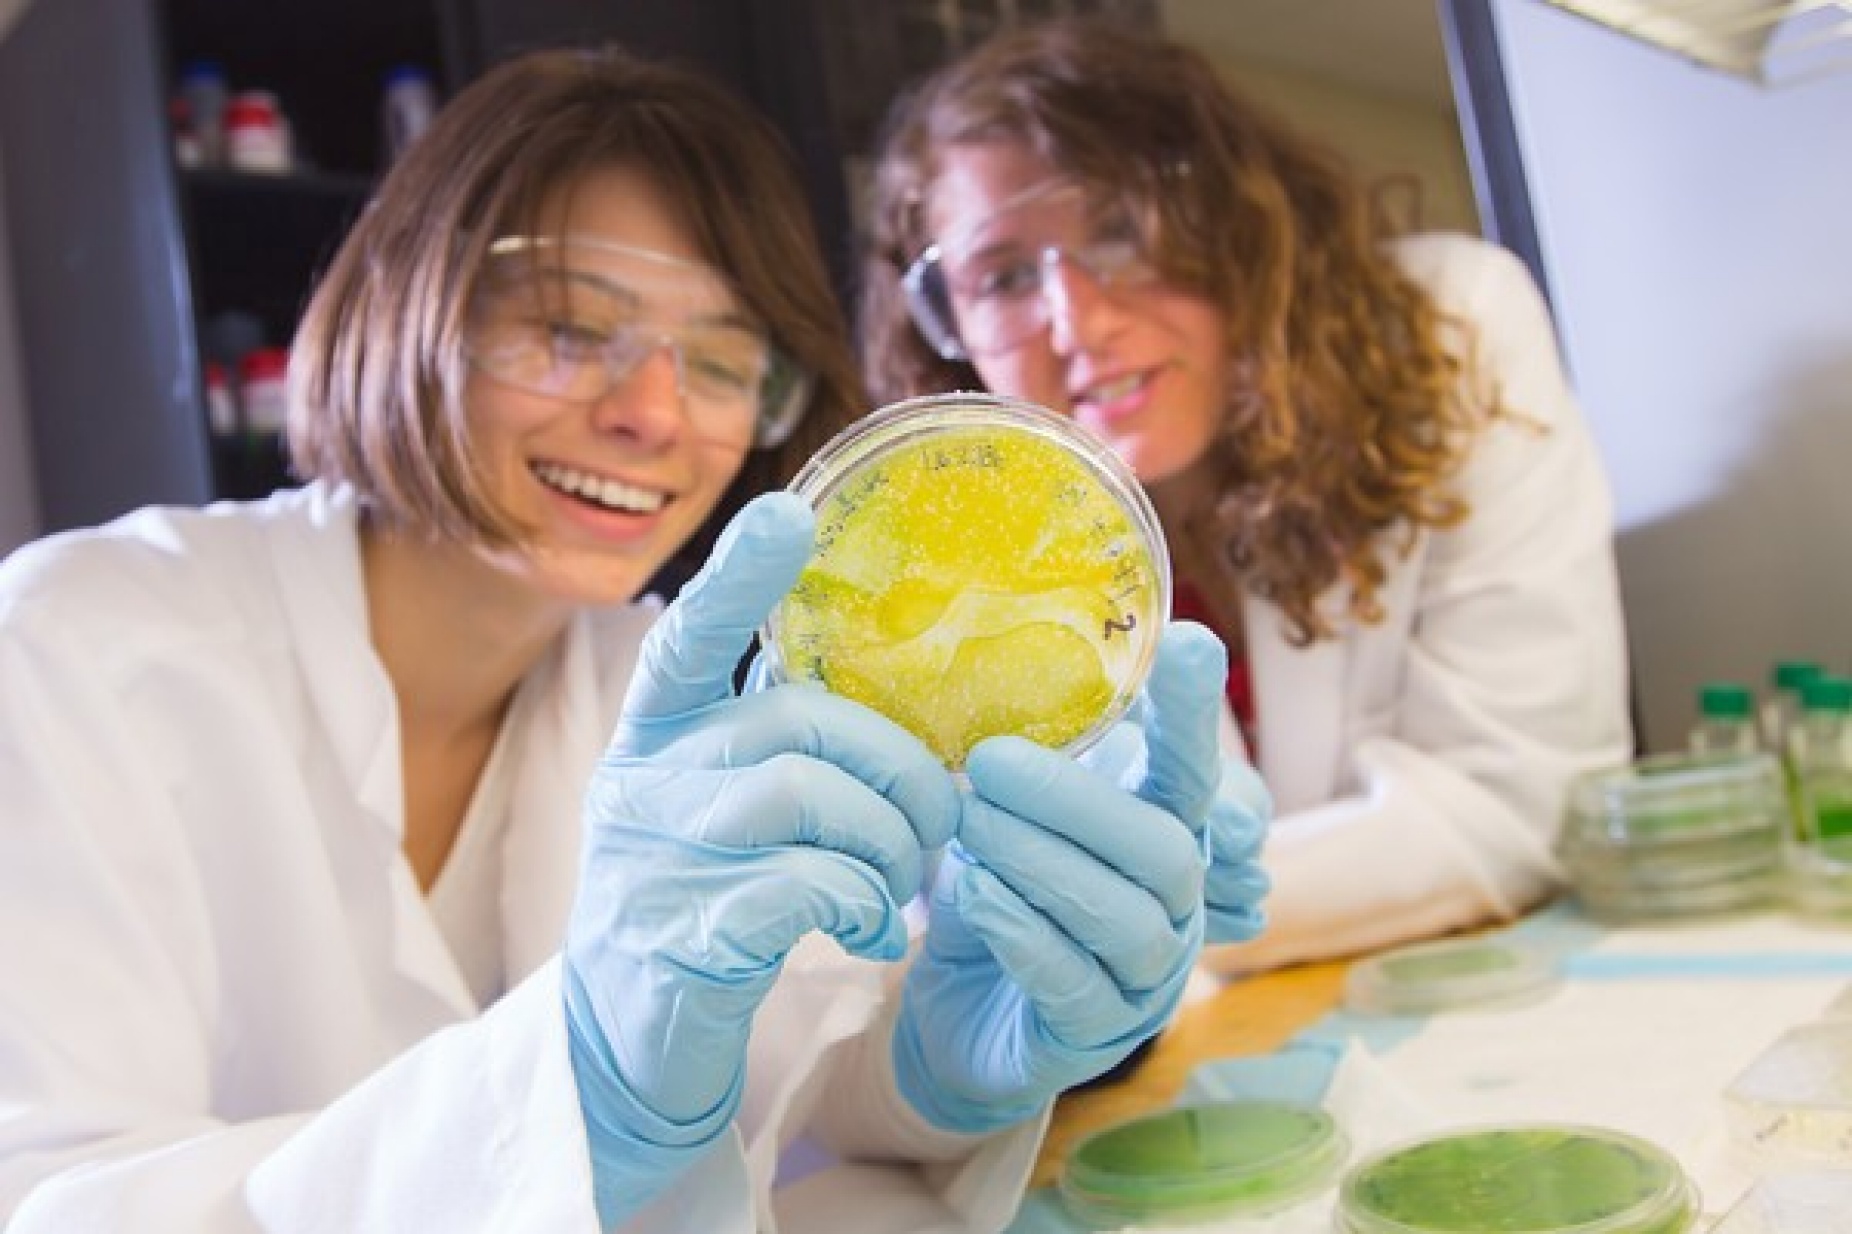
women wearing lab coats and googles in a research lab holding a petri dish filled with a yellow substance.

The goal of the annual Women in STEM Summit is to address the striking lack of women in the science, technology, engineering and math fields, a trend that is seen not only in university enrollments, but in the job market as well. Photo: Douglas Levere
Published March 23, 2017 This content is archived.
Tips for navigating the courses, cultures and organizations needed for women pursuing careers in STEM fields will be the topic of the keynote address at UB’s third annual Women in STEM summit on April 5.
Presented by the Women in STEM Cooperative, the summit will be held from 9:30 a.m. to 3 p.m. in the Student Union, North Campus.
The keynote address by JJ DiGeronimo, president of Tech Savvy Women, a national organization that provides strategies to companies seeking to attract, retain and promote women in technology fields, will take place at 10 a.m. in the Student Union Theater.
During her talk DiGeronimo, who has a computer information systems degree and 20 years of experience with technology startups in the Silicon Valley, will offer a “top 10 list” for women aspiring to advance from entry-level to leadership positions in STEM-based fields.
Other sessions at the summit will tackle such topics as successful networking, confronting gender bias in the classroom and salary-negotiation strategies.
The goal of the annual summit is to address the striking lack of women in the science, technology, engineering and math fields, a trend that is seen not only in university enrollments, but in the job market as well.
“Women in STEM continue to experience challenges in professions that are dominated by men,” says Kathleen Murphy, service manager of UB Computing and Information Technology Network and Classroom Services, and a co-founder of the Women in STEM Cooperative.
And this year’s summit aims to bring about real change by discussing not only why the issue exists, but how to solve it. Summit coordinators have broadened the scope of the discussions and tailored information to include people of different backgrounds and walks of life.
“We made a concentrated effort to emphasize solutions in our program,” Murphy says. “This year there are more sessions to choose from, depending on your interests. We are also introducing targeted sessions that will appeal to larger audiences, including students and professionals, women and men.”
Among the sessions focused on bringing men into the discussion are those that will discuss how to engage more men in institutional transformation and provide tips on becoming a male ally.
The concept of inclusion is a major focus of this year’s summit and is partly responsible for the success of previous summits about women in STEM, notes Murphy, who served as chair of the past two summits.
“Part of our appeal is that we are not affiliated with any one school or department. Our programs are inclusive by design and intended for the entire campus community,” she says.
“I think the conference is popular with women in STEM because we have succeeded in creating a common space for shared conversations and experiences,” she says. “When you are in the company of 300 other amazing women, you are no longer invisible. Hopefully, you leave our summit empowered and inspired.”
Danielle Lewis, program coordinator for the Women in Science and Engineering (WiSE) program and chair of this year’s summit, agrees there is value in “creating a space for students, faculty and staff in the STEM disciplines to come together, not just for networking purposes but also to gain knowledge and build skills.”
“It’s important for students to see that professional development is important at all stages of one’s career, regardless of gender,” Lewis says.
The Women in STEM Summit is free and open to the public, but registration is advised due to limited seating.
The summit is sponsored by WiSE, Blackstone LaunchPad at UB, Institute of Electrical and Electronics Engineers (IEEE) Buffalo, Phi Sigma Rho, Society of Women Engineers, Technical Societies Council, UB Department of Mathematics, UB’s Gender Institute, the Office of the Chief Information Officer, the School of Engineering and Applied Sciences, UB’s MBA Program and the University Honors College.